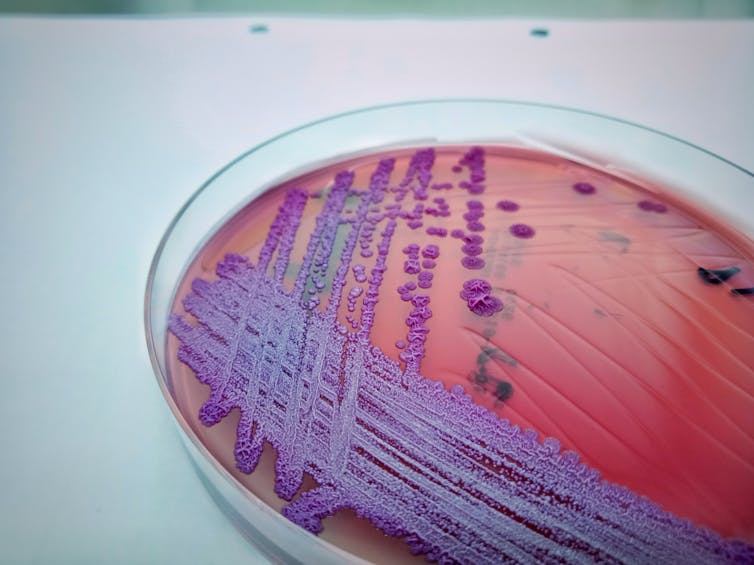

Since the start of this 12 months, the spread of deadly “mud bugs” in North Queensland has not diminished.
So far there’s 221 cases and 31 deaths From this disease in 2025. It has a 400 % increase in cairns cases and a rise of 600 % in Town Will over the past years.
Fortunately, the variety of cases has began to diminish. Queensland Health Reports New matters weeklyAnd within the recent reporting period – as of May 6 – seven recent cases were recorded, which was lower than 29 cases per week until February 16.
However, individuals are still contracting and To die from this disease. So is Queensland dynamic inland, and is there any promising vaccine on the horizon?
What is Melioidosis?
Myloidosis is attributable to the germs that live in soil, mud and groundwater, often no harm. But humans and animals may cause illness in the event that they enter the skin through a cut. Or can it breathe within the droplets of water and enter the lungs.
Is often taken to the disease One to four weeks To establish yourself, it means that individuals immediately exposed. After the symptoms don’t cause.
Myloidosis often offers as pneumonia. However, chronic infections of the skin, called skin infections, are present in 10-20 % of cases. Melioidosis may take Blood infection.
Symptoms of pneumonia form include fever, headache, difficulty respiratory, muscle aches, Chest pain and confusion.
We don’t understand skin infections in addition to lung infections with meloidosis. Skin infections are also less liable for standard antibiotic treatment as a consequence of the character of the chronic injury. For example, bacteria can form a skinny layer Is called biofilm. This may also help develop bacterial proteins that may prevent antibiotics from operating.
Myloidosis often occurs in tropical areas, reminiscent of Thailand. But it’s also considered Local in North AustraliaQueens Land and Northern Territories are found. However, the present outbreak in North Queensland is incredibly unusual.
Anyone can contract malidosis, but some medical conditions may Increase the risk of a person. These include diabetes, liver, kidney or lung disease, cancer, or other conditions that may compromise within the patient's immune system.
During the present Queensland outbreak 95 % of cases There have been individuals with risk aspects reminiscent of diabetes or lung disease.
How is Mylodosis spreading in Queensland?
Melioidosis increases during heavy rains and flood periods, and has been the identical In the current outbreak. However, the pattern has begun to emerge, which shows that the bacterium can now spread In other ways.
Experts have suggested that although Town Will cases may be described through floods and are related to a high level of rainfall, Cairns matters Not matching With this explanation.
Your photo/provided by Jamie Harvi
One suggestion is that the development of the Bruce Highway upgrade south of Cairns has increased matters as a consequence of clay particles. Become air -driven during construction.
This is just not a totally recent idea. The highway construction and investigation of soil transmission throughout the construction and concrete expansion has been investigated as a possible manner of transmission previous spikes of Melioidosis cases In Northern Queensland.
The Infrastructure Body liable for the upgrade has been promised Follow the expert health advice As the investigation is underway.
Can you be ready and turn into more fatal?
I This Possible Change How is the disease spreadingAnd the increasing variety of cases and deaths, can indicate that the organism is able to spread more easily and turn into more deadly. The genome evaluation is underway to find out this.
Especially, Bacteria found in the environment You can get gene from other bacteria in soil and water. This can improve their abilities to survive and be more flexible in inappropriate situations Changes to their natural residencePossibly affecting human hosts more effectively.
With rising rains, in the new climate, bacterium behind the meloidosis is prone to be a very important candidate for such a change.
Thebluehydrangea/shutter stock
What about treatment and protection?
The only technique to treat meloidosis is currently, which involves receiving diarrhea antibiotics within the hospital for several weeks, followed by Up to six months Oral antibiotics.
Against the background of quick calls Further research And there could also be hope on the horizon, increasing public awareness across the malidosis.
Researchers on the University of California have developed a vaccine that produces a protein that imitates protein This results in immune response to germs. The vaccine has been successful within the mouse model and can proceed to trial more animal trial, which, if successful, will result in human trials.
It seems that Myloidosis is an issue that is just not going away.
If you reside in an affected region like Tropical Queensland Or NtLimit maximum mud and water exposure. If you’re spending time in mud areas, use proper personal protective equipment reminiscent of gloves and shoes. If you’re working closely with water, you’ll be able to protect yourself by covering any open wounds and wearing breath.
Monitor the symptoms and meet the doctor if you happen to feel unwell. More information can also be available From Queensland Health.














Leave a Reply